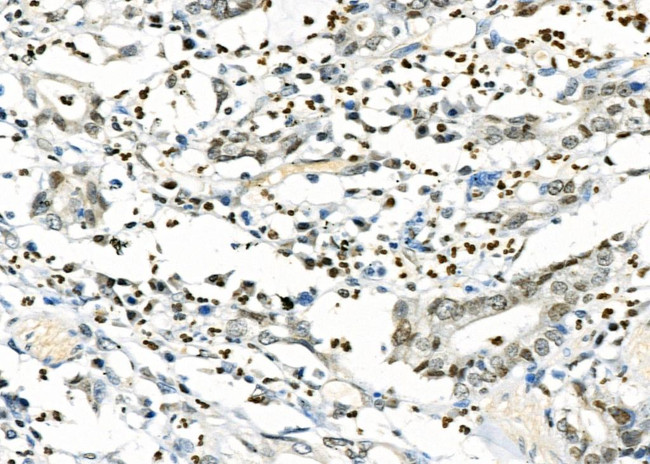
CD16 Antibody in Immunohistochemistry (Paraffin) (IHC (P))

Search
Invitrogen
CD16 Polyclonal Antibody
{{$productOrderCtrl.translations['antibody.pdp.commerceCard.promotion.promotions']}}
{{$productOrderCtrl.translations['antibody.pdp.commerceCard.promotion.viewpromo']}}
{{$productOrderCtrl.translations['antibody.pdp.commerceCard.promotion.promocode']}}: {{promo.promoCode}} {{promo.promoTitle}} {{promo.promoDescription}}. {{$productOrderCtrl.translations['antibody.pdp.commerceCard.promotion.learnmore']}}
图: 1 / 4
CD16 Antibody (PA5-106915) in IHC (P)




Please note: We are reviewing Western blot images included in the antibody testing data in our catalog, including those provided by third parties. Unless expressly labeled or annotated as “raw-unedited”, Western blot images included in the antibody testing data in our catalog may have been edited, optimized or otherwise adjusted for presentation.
产品信息
PA5-106915
种属反应
宿主/亚型
分类
类型
抗原
偶联物
形式
浓度
规格
纯化类型
保存液
内含物
保存条件
运输条件
RRID
产品详细信息
Antibody detects endogenous levels of total CD16.
靶标信息
CD16, known as Fc gamma receptor III, exists in two distinct isoforms: Fc gamma RIIIA and Fc gamma RIIIB. These isoforms are encoded by the genes FCGR3A and FCGR3B, respectively, which are located on chromosome 1 and share a high degree of similarity. Fc gamma RIIIA is expressed as a polypeptide-anchored form on monocytes, macrophages, and lymphocytes such as natural killer (NK) cells, but not on T or B cells. This receptor recognizes the Fc portion of immunoglobulin G (IgG) and is involved in the clearance of immune complexes from circulation. Upon binding IgG, Fc gamma RIIIA activates signal transduction pathways that result in antibody-dependent cell-mediated cytotoxicity (ADCC), phagocytosis, cytokine release, and antigen presentation. Fc gamma RIIIB is expressed on polymorphonuclear neutrophils (PMN) as a glycosylphosphatidylinositol (GPI)-anchored form. It plays a role in similar immune functions, including cellular-mediated cytotoxicity and enhancement of virus infections. Mutations in the FCGR3A gene have been associated with Immunodeficiency 20 and linked to susceptibility to recurrent viral infections, systemic lupus erythematosus, and alloimmune neonatal neutropenia. Alternatively spliced transcript variants encoding different isoforms have been identified for this gene. Diseases associated with FCGR3A include Immunodeficiency 20 and Herpes Zoster.
仅用于科研。不用于诊断过程。未经明确授权不得转售。
生物信息学
蛋白别名: CD16-2; CD16-I; CD16-II; CD16a; CD16a antigen; CD16b; CD32; CD32 receptor 2; CDw32; Fc fragment of IgG intermediate affinity IV receptor; Fc fragment of IgG, low affinity IIIa, receptor; Fc fragment of IgG, low affinity IIIa, receptor for (CD16); Fc fragment of IgG, low affinity IIIa, receptor for (CD16); Fc fragment of IgG, low affinity III, receptor for (CD16); Fc gamma receptor III; Fc gammaRIV; Fc receptor-like 3; Fc-gamma RII-b; Fc-gamma RII-c; Fc-gamma RIII; Fc-gamma RIII-alpha; Fc-gamma RIII-beta; Fc-gamma-RIIb; Fc-gamma-RIIc; Fcg receptor III; FCG2; FcgammaRIII; FcgammaRIV; FCGR2; FCGR2A; FCGR2B; FCGR2C; FcR-10; FcRII-b; FcRII-c; fcRIII; igG Fc receptor III; IgG Fc receptor III-1; IgG Fc receptor III-2; IgG Fc receptor III-A; low affinity immunoglobulin gamma Fc region receptor III; Low affinity immunoglobulin gamma Fc region receptor III-A; Low affinity immunoglobulin gamma Fc region receptor III-B; RP11-5K23.1; transmembrane receptor FcgammaRIII-X
基因别名: 4833442P21Rik; CD16; CD16-2; CD16A; CD16B; FCG3; FcgammaRIV; FCGR3; FCGR3A; FCGR3B; Fcgr4; FcgRIV; Fcrl3; IGFR3
UniProt ID: (Rat) Q6XPU4, (Mouse) A0A0B4J1G0
Entrez Gene ID: (Mouse) 14131, (Rat) 304966, (Mouse) 246256